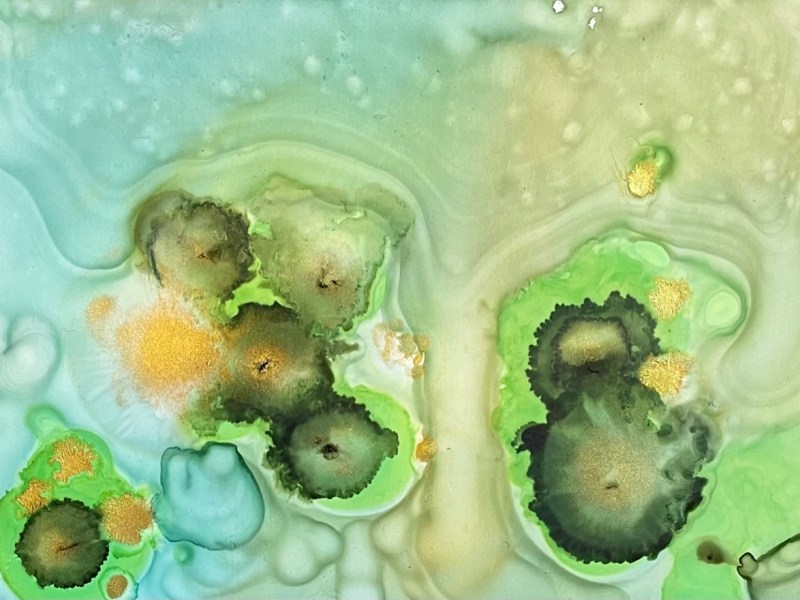
Sarah Mills | poetry | Moving On

poetry
Frances Klein | poetry | Better Half
“hand twice as tight on the railing”
Jenny M. Liu | poetry | Dear Disc Jockey
“it shines like a beaten egg”
Katie Kemple | poetry | Electric
“we were just college girls in pixie cuts”
Lydia Gompper | poetry | Ferris Wheel
“Our pinkies are brushing”
Logan Elizabeth Craig | poetry | If You Wash It, You Can Have It
“I want your lips around my straw”
Sarah Mills | poetry | Moving On
“Here you are inside another poem”
prose
Angela Townsend | nonfiction | Against Type
“I want to be the snow leopard on her peaceful mountain.”
Rachael Lane Stedman | nonfiction | Czech Fairy Tale
“I find a room to sublet for only one month”
Zach Murphy | fiction | The Mallards of St. Catherine
“Wildflowers painted the perimeter”
Nicole Bethune Winters | nonfiction | Remembering
“I pretend I am a fish and I follow the current”
Anna Dempsey | fiction | stopping by the roadside
“Sun’s out, sun’s out, sun’s out”
Cameron Marinne | fiction | You Are Loved
“The sexy one liners come off sounding like punch lines”

visual art